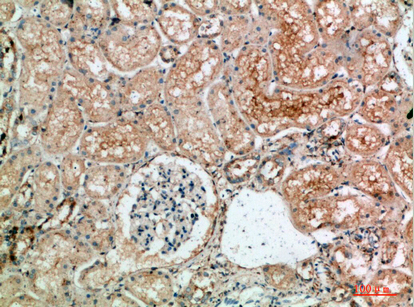

别名:similar to transducin-like enhancer of split 1/2/3/4应用:WB
反应种属:Human,Mouse,Rat
规格:50μl/100μl
| Description |
|---|
| Transcriptional corepressor that binds to a number of transcription factors. Inhibits NF-kappa-B-regulated gene expression. Inhibits the transcriptional activation mediated by FOXA2, and by CTNNB1 and TCF family members in Wnt signaling. |
| Specification | |
|---|---|
| Aliases | similar to transducin-like enhancer of split 1/2/3/4 |
| Entrez GeneID | 7088/7089/7090/7091 |
| Swissprot | Q04724/Q04725/Q04726/Q04727 |
| WB Predicted band size | Calculated MW: 83 kDa; Observed MW: 90 kDa |
| Host/Isotype | Rabbit IgG |
| Storage | Store at 4°C short term. Aliquot and store at -20°C long term. Avoid freeze/thaw cycles. |
| Species Reactivity | Human,Mouse,Rat |
| Immunogen | The antiserum was produced against synthesized peptide derived from the C-terminal region of human TLE1/TLE2/TLE3/TLE4. AA range:721-770 |
| Formulation | Liquid in PBS containing 50% glycerol, 0.5% BSA and 0.02% sodium azide, pH 7.3. |
| Application | |
|---|---|
| WB | 1/500-1/1000 |
| ELISA | 1/10000 |
![]() |
Western blot analysis of TLE1/2/3/4 in A549, 3T3, mouse liver, SH-SY5Y, K562 , Hela , 293T lysates using TLE1/2/3/4 antibody. |
![]() |
Immunohistochemistry analysis of paraffin-embedded Human breastcancer using TLE1/2/3/4 antibody.High-pressure and temperature Sodium Citrate pH 6.0 was used for antigen retrieval. |
![]() |
Immunohistochemistry analysis of paraffin-embedded Human breastcancer using TLE1/2/3/4 antibody. High-pressure and temperature Sodium Citrate pH 6.0 was used for antigen retrieval. |
![]() |
Immunohistochemistry analysis of paraffin-embedded Human kidney using TLE1/2/3/4 antibody.High-pressure and temperature Sodium Citrate pH 6.0 was used for antigen retrieval. |
![]() |
Immunohistochemistry analysis of paraffin-embedded Human kidney using TLE1/2/3/4 antibody.High-pressure and temperature Sodium Citrate pH 6.0 was used for antigen retrieval. |
本公司的所有产品仅用于科学研究或者工业应用等非医疗目的,不可用于人类或动物的临床诊断或治疗,非药用,非食用。
暂无评论
本公司的所有产品仅用于科学研究或者工业应用等非医疗目的,不可用于人类或动物的临床诊断或治疗,非药用,非食用。
中文

发表回复